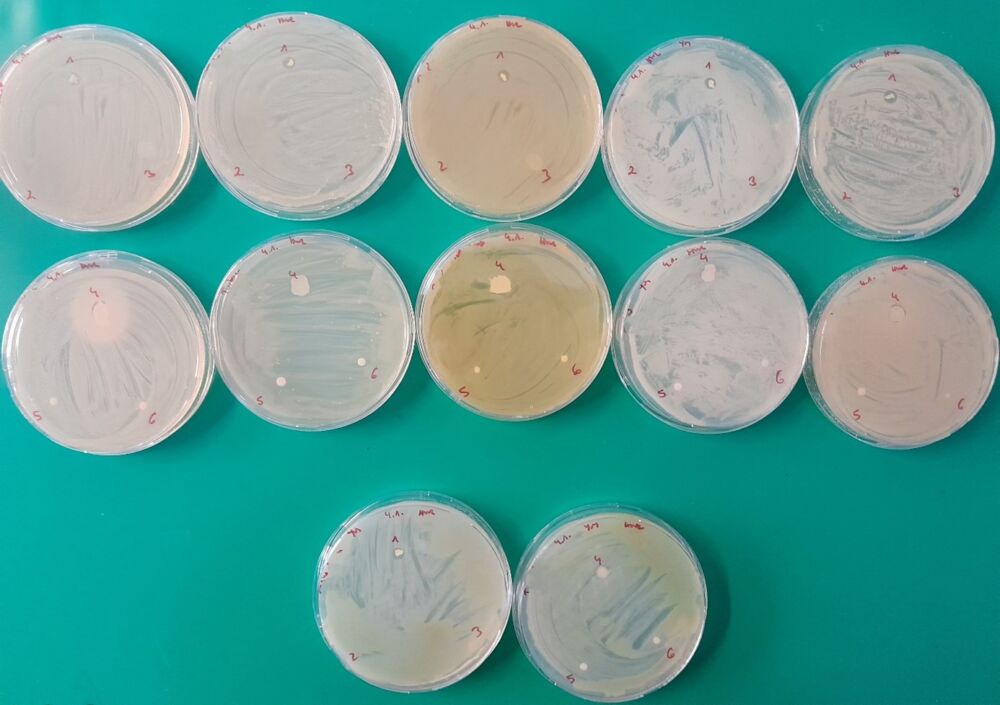

Ensemos SeedInjectionTM Technologie bring nützliche Mikroorganismen in Saatgut ein, um chemische Düngemittel und Pflanzenschutzmittel zu reduzieren. Dabei wird Saatgut im Hochdurchsatz aufgeschnitten, nützliche Mikroorganismen werden injiziert und der Schnitt wird mit einem Biopolymer wieder verschlossen. Bei der Entwicklung des optimalen Verschlussmaterials konnte im Netzwerk des Holzcluster Steiermark rasch der richtige Projektpartner für Ensemo in der FH Salzburg gefunden werden.
Gemeinsam mit Thomas Sepperer und Stefan Kain seitens der FH Salzburg sowie Birgit Mitter und Hanna Wolf von Ensemo wurden die Anforderungen an das Verschlussmaterial des Saatgutes definiert – wie zum Beispiel biologische Abbaubarkeit und Wasserstabilität.
Anfang Jänner 2024 konnten im Rahmen eines gemeinsamen Treffens an der FH in Kuchl von Stefan Kain und Thomas Sepperer verschiedenste Verschlussmöglichkeiten präsentiert werden, die nun von Hanna Wolf im Ensemo-eigenen Labor auf ihre Tauglichkeit hin untersucht werden – etwa im Rahmen von physikalischen und mikrobiologischen Tests. In weiterer Folge werden die im Vorfeld als geeignet ausgewählten Verschlussmaterialien in Keimversuchen überprüft. Dabei wird ausgeschlossen, dass das Verschlussmaterial negative Auswirkungen auf die Keimfähigkeit hat.